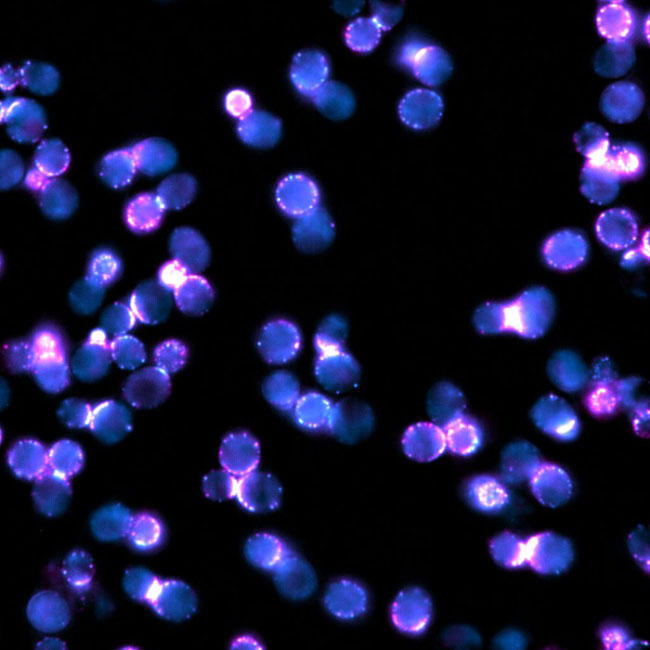

"AIM-Net provides a unique framework to bridge AI innovation and biological discovery, fostering truly multiscale understanding of life"
Ignacio Arganda-Carreras, Computer Vision and Pattern Discovery
G Pict Cat Cyan & Magenta
Resources
BUS-UCLM: Breast ultrasound lesion segmentation dataset
Computer Vision and Artificial Intelligence - Optics and Artificial Intelligence
CartoCell, a high-content pipeline for 3D image analysis, unveils cell morphology patterns in epithelia
Mechanisms of Tissue Organization
BiaPy: accessible deep learning on bioimages
Mechanisms of Tissue Organization
Computer Vision and Pattern Discovery
Computational Imaging for Biomedical Discovery
MAGIK - A Geometric Deep Learning Framework
QuBi lab
PyF2F: Robust and simplified fluorophore-to-fluorophore distance measurements
Biophysics in Cell Biology
SAMJ (Segment Anything for ImageJ/Fiji)
Computational Imaging for Biomedical Discovery
GNCnn: A QuPath extension for glomerulosclerosis and glomerulonephritis characterization based on deep learning
Computer Vision and Artificial Intelligence - Optics and Artificial Intelligence
Spatial Clustering of Molecular Localizations with MIRO
QuBi lab
Anomaly Detection applied to the Classification of Cytology Images
Grupo de Informática de la Universidad de La Rioja
Macro for Analysis of the blood vessels
Grupo de Informática de la Universidad de La Rioja
DeepTrackAI
QuBi lab
DeepImageJ
Computational Imaging for Biomedical Discovery
BioImage Model Zoo
Computational Imaging for Biomedical Discovery
The anomalous diffusion library
QuBi lab
Cell Tracking Challenge (CTC)
Computational Imaging for Biomedical Discovery
Publications
Filtered by author
Mesenchymal Stem Cells Sense the Toughness of Nanomaterials and Interfaces
Cellular and Molecular Biomechanics Laboratory
Lihui Peng, Carlos Matellan, Minerva Bosch-Fortea, Jordi Gonzalez-Molina, Matteo Frigerio, Stefan Salentinig, Armando del Rio Hernandez, Julien E. Gautrot
ReadRetinoic acid receptor β modulates mechanosensing and invasion in pancreatic cancer cells via myosin light chain 2
Cellular and Molecular Biomechanics Laboratory
Carlos Matellan, Dariusz Lachowski, Ernesto Cortes, Kai Ning Chiam, Aleksandar Krstic, Stephen D. Thorpe & Armando E. del Río Hernández
ReadThe Cell Tracking Challenge: 10 years of objective benchmarking
Computational Imaging for Biomedical Discovery
Martin Maška, Vladimír Ulman, Pablo Delgado-Rodriguez, Estibaliz Gómez-de-Mariscal, Tereza Nečasová, Fidel A. Guerrero Peña, Tsang Ing Ren, Elliot M. Meyerowitz, Tim Scherr, Katharina Löffler, Ralf Mikut, Tianqi Guo, Yin Wang, Jan P. Allebach, Rina Bao, Noor M. Al-Shakarji, Gani Rahmon, Imad Eddine Toubal, Kannappan Palaniappan, Filip Lux, Petr Matula, Ko Sugawara, Klas E. G. Magnusson, Layton Aho, Andrew R. Cohen, Assaf Arbelle, Tal Ben-Haim, Tammy Riklin Raviv, Fabian Isensee, Paul F. Jäger, Klaus H. Maier-Hein, Yanming Zhu, Cristina Ederra, Ainhoa Urbiola, Erik Meijering, Alexandre Cunha, Arrate Muñoz-Barrutia, Michal Kozubek & Carlos Ortiz-de-Solórzano
ReadInterpolAI: deep learning-based optical flow interpolation and restoration of biomedical images for improved 3D tissue mapping
Computational Imaging for Biomedical Discovery
Saurabh Joshi, André Forjaz, Kyu Sang Han, Yu Shen, Vasco Queiroga, Florin A. Selaru, Marie Gérard, Daniel Xenes, Jordan Matelsky, Brock Wester, Arrate Muñoz Barrutia, Ashley L. Kiemen, Pei-Hsun Wu & Denis Wirtz
ReadDT4PEIS: detection transformers for parasitic egg instance segmentation
Computer Vision and Artificial Intelligence - Optics and Artificial Intelligence
Ruiz-Santaquiteria, J., Pedraza, A., Deniz, O., & Bueno, G. DT4PEIS: detection transformers for parasitic egg instance segmentation. Applied Intelligence, 55(4), 271 (2025).
ReadGraph neural networks in the nephropathological diagnosis of antibody-mediated rejection
Computer Vision and Artificial Intelligence - Optics and Artificial Intelligence
Mateos-Aparicio-Ruiz, I., Pedraza, A., Altini, N., Gonzalez, L., & Bueno, G. Graph neural networks in the nephropathological diagnosis of antibody-mediated rejection. Computational and Structural Biotechnology Journal, Vol. 29, 271-285, (2025).
ReadMultimodal deep learning for cyanobacteria classification: a fusion of CNN and transformer architectures
Computer Vision and Artificial Intelligence - Optics and Artificial Intelligence
Blanco, M., Ruiz-Santaquiteria, J., Cristóbal, G., Perona, E., & Bueno, G. Multimodal deep learning for cyanobacteria classification: a fusion of CNN and transformer architectures. Aquatic Ecology, 59(4), 1319-1339, (2025).
ReadThe In Vivo Architecture of the Exocyst Provides Structural Basis for Exocytosis
Biophysics in Cell Biology
Picco, A., Irastorza-Azcarate, I., Specht, T., Böke, D., Pazos, I., Rivier-Cordey, A.-S., Devos, D.P., Kaksonen, M., Gallego, O. (2017) Cell 168, 400–412.e18
ReadBiaPy: accessible deep learning on bioimages
Computer Vision and Pattern Discovery / Mechanisms of Tissue Organization / Computational Imaging for Biomedical Discovery
Franco-Barranco, D., Andrés-San Román, J.A., Hidalgo-Cenalmor, I. et al. BiaPy: accessible deep learning on bioimages. Nat Methods 22, 1124–1126 (2025).
ReadA deep learning method that identifies cellular heterogeneity using nanoscale nuclear features
Computer Vision and Pattern Discovery
Carnevali, D., Zhong, L., González-Almela, E. et al. A deep learning method that identifies cellular heterogeneity using nanoscale nuclear features. Nat Mach Intell 6, 1021–1033 (2024).
ReadHSMix: Hard and soft mixing data augmentation for medical image segmentation
Computer Vision and Pattern Discovery
Sun, D., Dornaika, F. and Barrena, N., 2025. HSMix: Hard and soft mixing data augmentation for medical image segmentation. Information Fusion, 115, p.102741.
ReadThe diffraction limit of light taken by storm
Reprogramming & Regeneration laboratory
Cosma MP (2025). The diffraction limit of light taken by storm. Nature Reviews Molecular Cell Biology 26:498 (2025).
ReadThe relationship between nanoscale genome organization and gene expression in mouse embryonic stem cells during pluripotency transition
Reprogramming & Regeneration laboratory
GarateX, Gómez-García PA, Fernández Merino M, Cadevall Angles M, Zhu C, Castells-García A, Ed-daoui AI, Martin L, Ochiai H, Neguembor MV, Cosma MP (2024). The relationship between nanoscale genome organization and gene expression in mouse embryonic stem cells during pluripotency transition. Nucleic Acids Research 52(14):8146-8164 (2024).
ReadA deep learning method that identifies cellular heterogeneity using nanoscale nuclear features
Reprogramming & Regeneration laboratory
Carnevali D, Zhong L, González-Almela E, Viana C, Rotkevich M, Wang A, Franco-Barranco D, Gonzalez-Marfil A, Neguembor MV, Castells-Garcia A, *Arganda-Carreras I*, Cosma MP* (2024). A deep learning method that identifies cellular heterogeneity using nanoscale nuclear features. Nature Machine Intelligence 6(9):1021-1033 (2024).
ReadCartoCell, a high-content pipeline for 3D image analysis, unveils cell morphology patterns in epithelia
Mechanisms of Tissue Organization
Andrés-San Román, J.A., Gordillo-Vázquez, C., Franco-Barranco, D., Morato, L., Tagua, A., Vicente-Munuera, P., Palacios, A.M., Gavilán, M.P., Annese, V., Gómez-Gálvez, P. #, Arganda-Carreras, I. # and Escudero, L.M. # (2023). CartoCell, a high-throughput pipeline for accurate 3D image analysis, unveils cell morphology patterns in epithelial cysts. Cell Reports Methods Oct 23;3(10).
ReadComputational Analysis of SOD1-G93A Mouse Muscle Biomarkers for Comprehensive Assessment of ALS Progression
Mechanisms of Tissue Organization
Gómez-Gálvez, P. #, Navarro, V., Castro, A. M., Paradas, C. #, Escudero, L.M.# (2025). Computational analysis of SOD1-G93A mouse muscle biomarkers for comprehensive assessment of ALS progression. Neuropathology and Applied Neurobiology 51 (2).
ReadContinuum architecture dynamics of vesicle tethering in exocytosis
Biophysics in Cell Biology
Puig-Tintó, M., Ortiz, S., Meek, S., Coray, R., Hernández, A., Castellet, A., Kramer, E., Betancur, L., Hoess, P,. Mund, M., Izquierdo-Serra, M., Baldo, O., de Marco, A., Ries, J., Castaño-Díez, D. Manzo, C. Gallego, O. (2025) BioRxiv
ReadPyF2F: a robust and simplified fluorophore-to-fluorophore distance measurement tool for Protein interactions from Imaging Complexes after Translocation experiments
Biophysics in Cell Biology
Hernandez, AC, Ortiz, S, Betancur, LI, Dojčilović, R, Picco, A, Kaksonen, M, Oliva, B, and Gallego, O*. (2024) NAR Genom Bioinform, 6(1):lqae027.
ReadAnomaly detection applied to the classification of cytology images
Grupo de Informática de la Universidad de La Rioja
Marta, C.B., Doblare, M., Heras, J., Mata, G. and Ramirez, T., 2025. Anomaly detection applied to the classification of cytology images. Biomedical Signal Processing and Control, 105, p.107625.
ReadComputer vision for automatic identification of blastocyst structures and blastocyst formation time in In-Vitro Fertilization
Grupo de Informática de la Universidad de La Rioja
Villota, M., Ayensa-Jiménez, J., Malo, C., Urries, A., Doblaré, M. and Heras, J., 2025. Computer vision for automatic identification of blastocyst structures and blastocyst formation time in In-Vitro Fertilization. Computers in Biology and Medicine, 196, p.110633.
ReadSpatial Clustering of Molecular Localizations with Graph Neural Networks
QuBI Lab
Jesús Pineda, Sergi Masó-Orriols, Joan Bertran, Mattias Goksör, Giovanni Volpe, Carlo Manzo
ReadGeometric deep learning reveals the spatiotemporal features of microscopic motion
QuBI Lab
Mirja Granfors, Jesús Pineda, Blanca Zufiria Gerbolés, Joana B. Pereira, Carlo Manzo, Giovanni Volpe
ReadGlobal graph features unveiled by unsupervised geometric deep learning
QuBI Lab
Jesús Pineda, Benjamin Midtvedt, Harshith Bachimanchi, Sergio Noé, Daniel Midtvedt, Giovanni Volpe, Carlo Manzo
ReadThe impact of a high fat diet and platelet activation on pre-metastatic niche formation
Advanced Optical Microscopy Unit / Grupo de Informática de la Universidad de La Rioja
Hergueta-Redondo M, Sánchez-Redondo S, Hurtado B, Santos V, Pérez-Martínez M, Ximénez-Embún P, McDowell SAC, Mazariegos MS, Mata G, Torres-Ruiz R, Rodríguez-Perales S, Martínez L, Graña-Castro O, Megias D, Quail D, Quintela-Fandino M, Peinado H. The impact of a high fat diet and platelet activation on pre-metastatic niche formation. Nat Commun. 2025 Apr 2;16(1):2897.
ReadA clinically compatible drug-screening platform based on organotypic cultures identifies vulnerabilities to prevent and treat brain metastasis
Advanced Optical Microscopy Unit
Zhu L, Retana D, García-Gómez P, Álvaro-Espinosa L, Priego N, Masmudi-Martín M, Yebra N, Miarka L, Hernández-Encinas E, Blanco-Aparicio C, Martínez S, Sobrino C, Ajenjo N, Artiga MJ, Ortega-Paino E, Torres-Ruiz R, Rodríguez-Perales S; RENACER; Soffietti R, Bertero L, Cassoni P, Weiss T, Muñoz J, Sepúlveda JM, González-León P, Jiménez-Roldán L, Moreno LM, Esteban O, Pérez-Núñez Á, Hernández-Laín A, Toldos O, Ruano Y, Alcázar L, Blasco G, Fernández-Alén J, Caleiras E, Lafarga M, Megías D, Graña-Castro O, Nör C, Taylor MD, Young LS, Varešlija D, Cosgrove N, Couch FJ, Cussó L, Desco M, Mouron S, Quintela-Fandino M, Weller M, Pastor J, Valiente M. A clinically compatible drug-screening platform based on organotypic cultures identifies vulnerabilities to prevent and treat brain metastasis. EMBO Mol Med. 2022 Mar 7;14(3):e14552.
ReadQuantitative characterization of membrane-protein reversible association using FCS
Single Molecule Optical Spectroscopy
A. G. Vesga, L. Villegas, C.C. Vequi-Suplicy, C.O.S. Sorzano, Jose Requejo-Isidro*Quantitative characterization of membrane-protein reversible association using FCS. Biophysical Journal (2023) 122(11):2285-2300.
ReadA Common CTRB misfolding variant associated with pancreatic cancer risk causes ER stress and inflammation in mice
Conofocal Microscopy Unit
Cristina Bodas, Irene Felipe, Brice Chanez, Miguel Lafarga, Evangelina Lopez de Maturana, Jaime Martinez de Villarreal, Natalia Del Pozo, Marina Malumbres, Pierfrancesco Vargiu, Ana Cayuela, Isabel Peset, Katelyn Connelly, Jason Hoskins, Raúl Méndez, Laufey Amundadottir, Núria Malats, Sagrario Ortega, Francisco X Real
Readc-MET/VEGFR-2 co-localisation impacts on survival following bevacizumab therapy in epithelial ovarian cancer: an exploratory biomarker study of the phase 3 ICON7 trial
Conofocal Microscopy Unit
Robert D. Morgan, Cristina Ferreras, Isabel Peset, Egle Avizienyte, Andrew G. Renehan, Richard J. Edmondson, Alexander D. Murphy, Shibani Nicum, Thomas Van Brussel, Andrew R. Clamp, Diether Lambrechts, Cong Zhou, Gordon C. Jayson
ReadDiffusion model comparison identifies distinct tumor sub-regions and tracks treatment response
Conofocal Microscopy Unit
Damien J McHugh, Grazyna Lipowska-Bhalla, Muhammad Babur, Yvonne Watson, Isabel Peset, Hitesh B Mistry, Penny L Hubbard Cristinacce, Josephine H Naish, Jamie Honeychurch, Kaye J Williams, James P B O'Connor, Geoffrey J M Parker
ReadA deep learning method that identifies cellular heterogeneity using nanoscale nuclear features
Chromatin Folding and Nanoscopy
Carnevali D, Zhong L, González-Almela E, Viana C, Rotkevich M, Wang A, Franco-Barranco D, Gonzalez-Marfil A, Neguembor MV, Castells-Garcia A, Arganda-Carreras I, Cosma MP.Nat Mach Intell. 2024;6(9):1021-1033. doi: 10.1038/s42256-024-00883-x. Epub 2024 Aug 27.PMID: 39309215Free PMC article.
ReadTranscription-mediated supercoiling regulates genome folding and loop formation
Chromatin Folding and Nanoscopy
Neguembor MV, Arcon JP, Buitrago D, Lema R, Walther J, Garate X, Martin L, Romero P, AlHaj Abed J, Gut M, Blanc J, Lakadamyali M, Wu CT, Brun Heath I, Orozco M, Dans PD, Cosma MP.Nat Struct Mol Biol. 2022 Oct;29(10):1011-1023. doi: 10.1038/s41594-022-00839-y. Epub 2022 Oct 11.PMID: 36220894
ReadThe Cell Tracking Challenge: 10 years of objective benchmarkin
Laboratory of Microphysiological Systems and Quantitative Biology
Maška M., Ulman V., Delgado-Rodriguez P., Gómez-de-Mariscal E., Nečasová T., Guerrero Peña F.A., Ren T.I., Meyerowitz E.M., Scherr T., Löffler K., Mikut R., Guo T., Wang Y., Allebach J.P., Bao R., Al-Shakarji N.M., Rahmon G., Toubal I.E., Palaniappan K., Lux F., Matula P., Sugawara K., Magnusson K.E.G, Aho L., Cohen A.R., Arbelle A., Ben-Haim T., Raviv T.R., Isensee F., Jäger P.F., Maier-Hein K.H., Zhu Y., Ederra C., Urbiola A., Meijering E., Cunha A., Muñoz-Barrutia A., Kozubek M., Ortiz-de-Solórzano C. Nature Methods 20 :1010-1020 (2023)
ReadSynplex: In Silico Modeling of the Tumor Microenvironment From Multiplex Images
Laboratory of Microphysiological Systems and Quantitative Biology
Jiménez-Sánchez D., Ariz M., De Andrea C.E., Ortiz-de-Solórzano C. IEEE Transactions on Medical Imaging 42(10):3048-3058 (2023)
ReadMiOS, an integrated imaging and computational strategy to model gene folding with nucleosome resolution
Chromatin Folding and Nanoscopy
Neguembor MV, Martin L, Castells-García Á, Gómez-García PA, Vicario C, Carnevali D, AlHaj Abed J, Granados A, Sebastian-Perez R, Sottile F, Solon J, Wu CT, Lakadamyali M, Cosma MP.Mol Cell. 2021 Aug 5;81(15):3065-3081.e12. doi: 10.1016/j.molcel.2021.06.009. Epub 2021 Jul 22.PMID: 34297911
ReadNaroNet: Discovery of tumor microenvironment elements from highly multiplexed images
Laboratory of Microphysiological Systems and Quantitative Biology
NaroNet: Discovery of tumor microenvironment elements from highly multiplexed images Laboratory of Microphysiological Systems and Quantitative Biology Jiménez-Sánchez D., Ariz M., Chang H., Matias-Guiu, de Andrea C.E., Ortiz-de-Solórzano C. Medical Image Analysis 78:102384. (2022)
Read